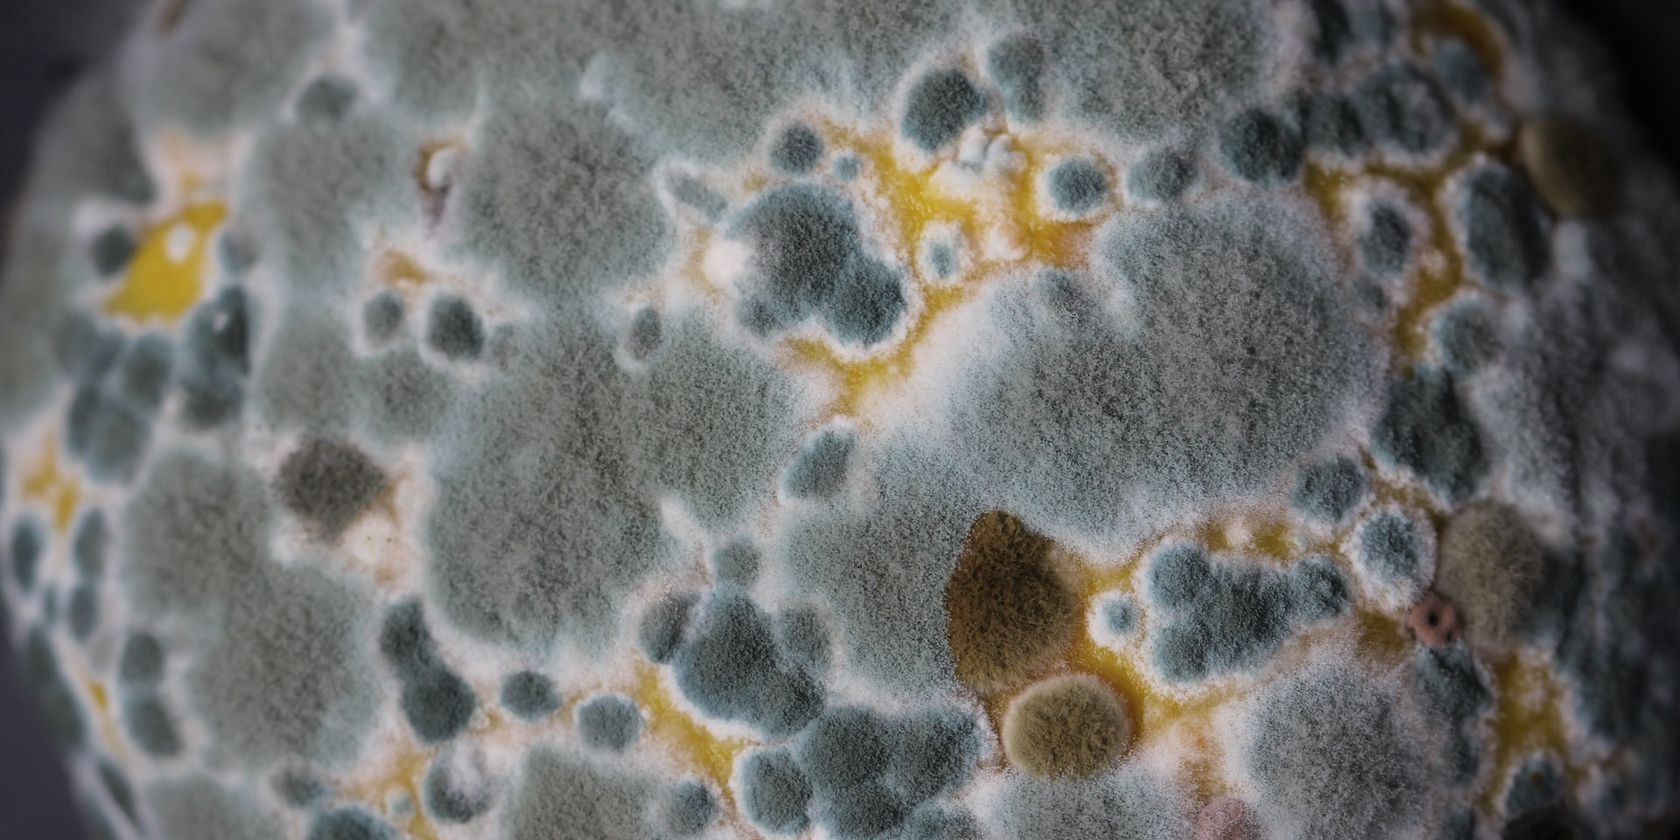

برنج مشکلات شما را حل نمی کند.
آیا فکر می کنید انداختن یک دستگاه الکترونیکی خیس در کیسه برنج آن را به حالت کار باز می گرداند؟ متأسفانه، این تکنیک کاری برای آن انجام نمی دهد.
زمان آن فرا رسیده است که به این تصور غلط پایان دهیم و راه حل واقعی را بپذیریم. اگر اقدامات درست را انجام دهید، می توانید از آسیب بیشتر جلوگیری کنید و ابزار خود را نجات دهید.
چرا برنج یک افسانه برای رفع آسیب آب است؟
اگر در وب برای گزینههای DIY برای رفع آسیبهای آب جستجو کردهاید، به احتمال زیاد این توصیه را دیدهاید: «آن را در برنج قرار دهید». خوب، نکن. برنج به عنوان راه حلی برای آسیب آب صرفاً یک افسانه شهری است که در چند سال اخیر مورد توجه زیادی قرار گرفته است.
برخی از مقالات خودیاری توضیح میدهند که برنج «رطوبتبینی» است، زیرا یک دانه است، اما هیچ مدرک علمی این را تأیید نمیکند. آنها احتمالاً به دلیل شباهت برنج به سیلیکاژل که آب را استخراج می کند، به این نتیجه رسیده اند.
چرا برنج برای رفع آسیب آب مضر است؟
ممکن است تعجب کنید، “چه چیز بدی در مورد استفاده از برنج برای آسیب آب وجود دارد؟” خیلی چیزها ممکن است اشتباه شود.
دانههای برنج ریز هستند و میتوانند وارد فضاها و درگاههایی شوند که از قبل دارای رطوبت هستند. با زمان کافی، غذا و آب در یک منطقه کوچک می تواند کپک ایجاد کند. و قالب هرگز در هیچ کجا خوب نیست، چه رسد به مادربرد لپ تاپ یا پنل تلفن شما.
در واقع برنج بیش از آنکه مفید باشد ضرر دارد. این می تواند رطوبت را برای مدت طولانی تری در دستگاه شما نگه دارد و احتمال خوردگی را افزایش دهد. علاوه بر این، دانههای متورم میتوانند بر قسمتهای ظریف مدارهای دستگاه شما فشار وارد کنند و در نتیجه آن را از کار بیاندازند.
مگر اینکه به درگاه های کپک زده، مسدود و بدبوی دستگاه خود وارد شده اید، اگر آن را در آب انداختید، آن را در برنج دفن نکنید. گزینه های بهتری وجود دارد؛ خواهی دید!
برای رفع آسیب آب چه کاری باید انجام دهید
اگر دستگاه شما زودتر نجات داده شود و بلافاصله در گونی برنج غوطه ور نشود، آسیب آب قابل تعمیر است. در صورت آسیب آب، باید در اسرع وقت آب بیشتری از دستگاه خود خارج کنید.
در اینجا چند مرحله ساده وجود دارد که باید هنگام خیس شدن دستگاه خود انجام دهید.
1. آن را خاموش کنید

آب یا رطوبت داخل کامپیوتر شما می تواند یکی از دلایلی باشد که لپ تاپ شما به شما شوک الکتریکی می دهد. این خطرناک است، بنابراین باید فورا آن را خاموش کنید. در صورت امکان، باتری و سایر قطعات قابل جابجایی آن مانند سینی سیم کارت را خارج کنید. این به آنها حداکثر قرار گرفتن در معرض هوا را می دهد و به خشک شدن آنها کمک می کند.
2. آن را خشک کنید
دستگاه را به آرامی با یک پارچه نرم پاک کنید تا رطوبت باقیمانده از بین برود. برای تحریک خشک شدن می توانید دستگاه را با الکل مالش دهید. با این حال، از این به مقدار کم استفاده کنید.
همچنین، از استفاده از دستمال کاغذی یا دستمال کاغذی خودداری کنید، زیرا ممکن است ذراتی از خود باقی بگذارند که باعث آسیب بیشتر شود.
3. آب را استخراج کنید

یک جاروبرقی دستی یا یک فن با سرعت پایین باید پس از خشک کردن دستگاه با یک پارچه نرم، مقدار کمی از رطوبت باقیمانده را استخراج کند. اگر یکی ندارید، می توانید یکی از بهترین جاروبرقی های دستی را به صورت آنلاین خریداری کنید یا به جای آن یک جاروبرقی DIY بسازید.
بسته های سیلیکا می توانند به جذب رطوبت نیز کمک کنند. همچنین می توانید از یک برنامه برای کمک به خروج آب از بلندگوها و میکروفون های آیفون خود استفاده کنید.
فقط مطمئن شوید که از سشوار، مایکروویو یا دیگر منابع حرارتی مصنوعی برای خشک کردن دستگاه استفاده نمیکنید، زیرا این کار میتواند بیشتر از اینکه مفید باشد، ضرر داشته باشد.
4. کمک حرفه ای دریافت کنید
هنگامی که دستگاه نسبتاً خشک شد، آن را برای هر گونه علائم آسیب بررسی کنید. در صورت مشاهده هر گونه مشکل، دستگاه را به تعمیرگاه حرفه ای ببرید.
حتی اگر هیچ مشکل واضحی را مشاهده نکردید، فقط برای اطمینان میتوانید دستگاه را برای نظر دوم به متخصص ببرید. از این گذشته، شما نمی خواهید روز خود را بگذرانید و فکر کنید که رایانه شما مشکلی ندارد، فقط با علائمی روبرو می شوید که نشان می دهد لپ تاپ شما در صورت نیاز دچار آسیب آب شده است.
5. پیشگیری کلیدی است
جلوگیری از آسیب آب به تعمیر بعداً ارجح است. از این گذشته، هیچ کس استرس و دردسر خشک کردن وسایل خود را نمی خواهد. علاوه بر این، تعمیر لوازم الکترونیکی خیس می تواند گران شود یا بدتر شود. شما باید آنها را به طور کامل جایگزین کنید.
در صورت امکان، از دستگاه خود در نزدیکی آب استفاده نکنید. همچنین در صورت امکان باید از محیط های مرطوب اجتناب کنید تا از ایجاد رطوبت در داخل آن جلوگیری کنید.
برنج خوب است، اما برای دستگاه شما نیست
برنج یک غذای اصلی است، اما راه حلی برای دستگاه های آسیب دیده از آب نیست. به این افسانه شهری نخورید که برنج آسیب آب را معکوس می کند تا دستگاه خود را گم نکنید.
همچنین، حتی اگر گوشی هوشمند یا دستگاه الکترونیکی شما دارای رتبه IP باشد، به این معنی نیست که ضد آب است و می توانید آزادانه آن را در آب غوطه ور کنید. به هر حال، بهتر است که در امان باشید تا متاسف باشید.